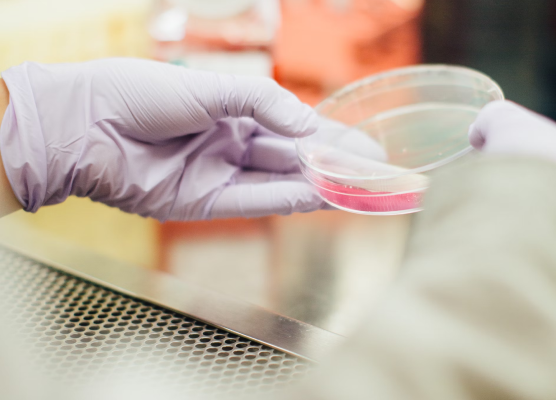

Система автоматизации лаборатории, с которой легко
Система управления и автоматизации процессов, которая помогает лаборатории идти в будущее, выводя эффективность на новый уровень

@limslims
@limslims
Для самых разных отраслей
4
Интеграции
С любыми ERP системами, в том числе 1С, Мегаплан, Cifra, а также лабораторным оборудованием.

Легко внедрить
Снижаем риски, оставляя максимум свободы для ваших решений о процессе работы лаборатории

Внедряем систему поэтапно, анализируя все аспекты и опираясь на обратную связь от вас

Адаптируем систему под особенности вашей лаборатории на каждом этапе внедрения
Легко изучить
Задача LIMS — упрощать, а не усложнять жизнь лаборатории

Включаем в систему только то, что нужно сотрудникам лаборатории

Учитываем привычные для вас процессы, инструменты и термины при настройке системы

Переиспользуем существующие решения, если есть возможность
Легко пользоваться
Ключ к эффективности — дать возможность сотрудникам фокусироваться на главном

Минимум ручных задач: голосовой ввод, автозаполнение, автоматизация рутины

Умные помощники: чат-боты, генерация отчетов, быстрый доступ к аналитике

Гибкость после внедрения: K-LIMS помогает адаптироваться к новым изменениям и работать над ошибками


Из чего состоит K-LIMS

Ядро системы — сверхгибкая платформа, позволяющая создать ваш собственный LIMS с учетом особенностей конкретной лаборатории

Поверх ядра, мы настраиваем удобные мобильные и веб-приложения, адаптированные под задачи сотрудников лаборатории

Дополнительно — умные инструменты для повышения эффективности: построенные на базе AI аналитические инструменты, чат-боты и голосовые помощники

Из чего состоит K-LIMS



Ядро системы — сверхгибкая платформа, позволяющая создать ваш собственный LIMS с учетом особенностей конкретной лаборатории

Поверх ядра, мы настраиваем удобные мобильные и веб-приложения, адаптированные под задачи сотрудников лаборатории

Дополнительно — умные инструменты для повышения эффективности: построенные на базе AI аналитические инструменты, чат-боты и голосовые помощники